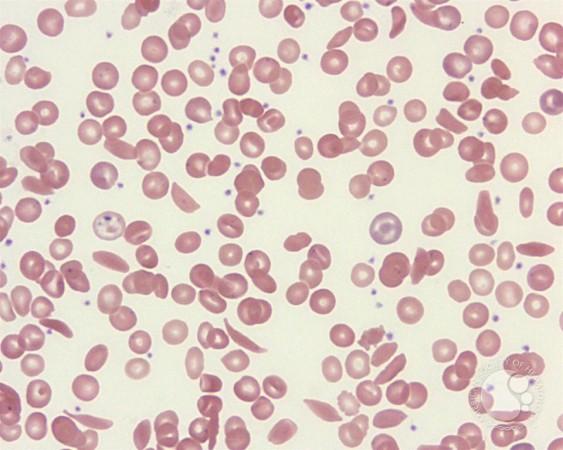
India launches 1st indigenous CRISPR-based gene therapy for Sickle Cell Disease

Setting a new milestone in Atmanirbhar Bharat, the government on Wednesday launched an indigenous CRISPR-based gene therapy for Sickle Cell Disease, which particularly affects India's tribal population.
The world-class, low-cost gene editing solution named "BIRSA 101", in honour of Bhagwan Birsa Munda, remembered as a great tribal freedom fighter, was launched by Union Minister of State (Independent Charge) for Science and Technology Dr. Jitendra Singh.
The technology works like a "precise genetic surgery", capable not only of curing Sickle Cell Disease but also transforming treatment pathways for several hereditary disorders, the Minister explained.
Sickle Cell Disease is a chronic, single-gene disorder that causes a debilitating systemic syndrome characterised by chronic anaemia, acute painful episodes, organ infarction, and chronic organ damage, significantly reducing life expectancy.
The genetic blood disorder affects the entire life of the patient, as it leads to various severe health complications.
"India has formally begun its decisive journey towards becoming a Sickle Cell Disease–free nation, marking a historic turning point in the country's public health and genomic medicine landscape," Singh said.
"With the development and transfer of India's first indigenous CRISPR-based gene therapy, the nation has taken a major step toward fulfilling Prime Minister Narendra Modi's vision of a Sickle Cell–Free India by 2047, while simultaneously advancing the goal of Atmanirbhar Bharat in frontline medical technologies," he added.
The breakthrough therapy, developed at CSIR-Institute of Genomics and Integrative Biology (IGIB), has demonstrated India's capability to produce pathbreaking therapies at a fraction of global costs, potentially replacing treatments priced at Rs 20-25 crore overseas.
IGIB has entered into a formal technology transfer and collaboration agreement with the Pune-based Serum Institute of India to scale up the engineered enFnCas9 CRISPR platform into affordable therapies for Sickle Cell Disease and other critical genetic disorders.
"Globally, gene therapies cost over three million dollars and are beyond the reach of even the wealthy. Our mission is to take Indian innovation and make it accessible for the poorest of the poor," said Dr. Umesh Shaligram, Executive Director, Serum Institute of India.
(With inputs from IANS)




